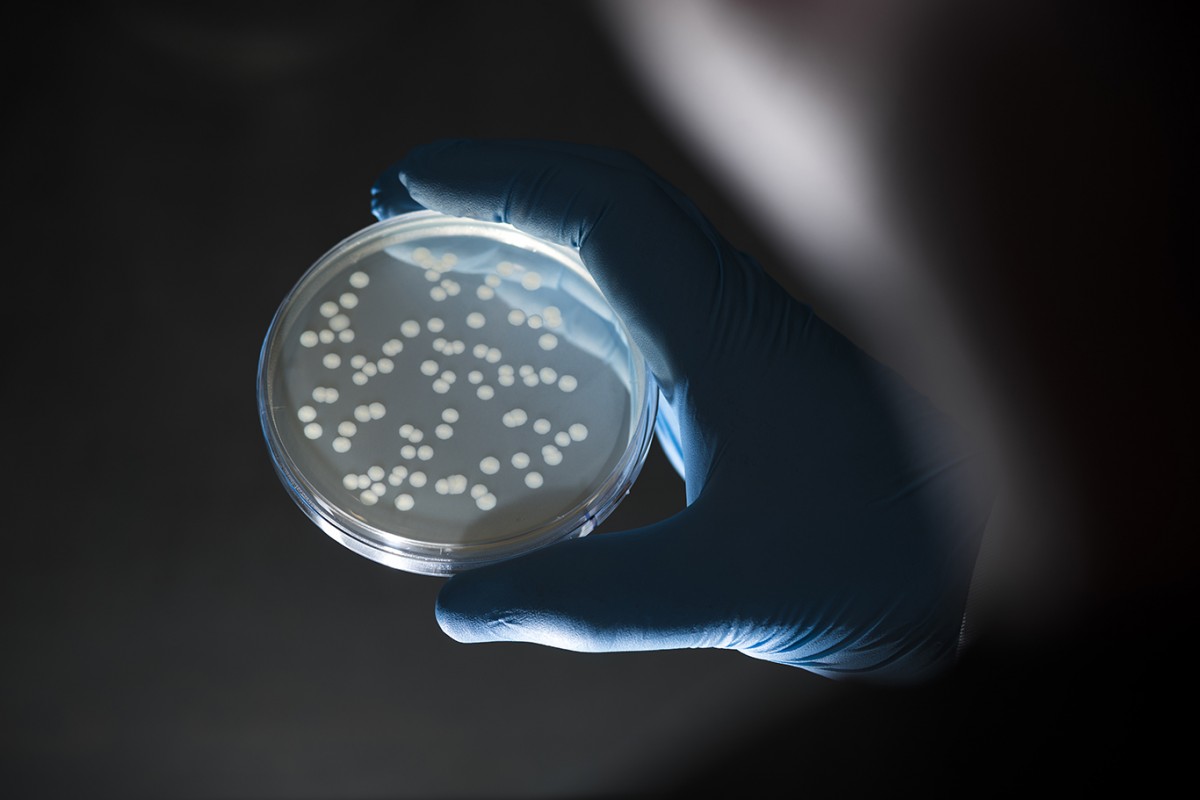

Make
Humans like to make things.
Some of these things are massive in scale and basic in principal, some are the opposite.
Making things look good is the basis of what I work toward.
(big or small)










































Humans like to make things.
Some of these things are massive in scale and basic in principal, some are the opposite.
Making things look good is the basis of what I work toward.
(big or small)